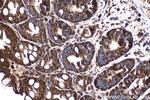
SMAD2 Antibody in Immunohistochemistry (Paraffin) (IHC (P))

Search
Proteintech
SMAD2 Polyclonal Antibody
{{$productOrderCtrl.translations['antibody.pdp.commerceCard.promotion.promotions']}}
{{$productOrderCtrl.translations['antibody.pdp.commerceCard.promotion.viewpromo']}}
{{$productOrderCtrl.translations['antibody.pdp.commerceCard.promotion.promocode']}}: {{promo.promoCode}} {{promo.promoTitle}} {{promo.promoDescription}}. {{$productOrderCtrl.translations['antibody.pdp.commerceCard.promotion.learnmore']}}
产品信息
12570-1-AP
种属反应
已发表种属
宿主/亚型
分类
类型
抗原
偶联物
形式
浓度
规格
纯化类型
保存液
内含物
保存条件
运输条件
产品详细信息
This antibody is a rabbit polyclonal antibody raised against residues near the N terminus of human SMAD2. The molecular weight of unphosphorylated forms of Smad2 is 52 kDa and phosphorylated forms of Smad2 is 58 kDa.
Immunogen sequence: MSSILPFTP PVVKRLLGWK KSAGGSGGAG GGEQNGQEEK WCEKAVKSLV KKLKKTGRLD ELEKAITTQN CNTKCVTIPS TCSEIWGLST PNTIDQWDTT GLYSFSEQTR SLDGRLQVSH RKGLPHVIYC RLWRWPDLHS HHELKAIENC EYAFNLKKDE VCVNPYHYQR VETPVLPPVL VPRHTEILTE LPPLDDYTHS IPENTNFPAG IEPQSNYIPE TPPPGYISED GETSDQQLNQ SMDTGSPAEL SPTTLSPVNH SLDLQPVTYS EPAFWCSIAY YELNQRVGET FHASQPSLTV DGFTDPSNSE RFCLGLLSNV NRNATVEMTR RHIGRGVRLY YIGGEVFAEC LSDSAI (1-355 aa encoded by B C014840)
靶标信息
SMAD2 (MADH2, MAD2) regulates multiple cellular processes, such as cell proliferation, apoptosis, and differentiation. SMAD2 interacts with the TGF-beta receptors through its interaction with the SMAD anchor for receptor activation into the nucleus is a central event in TGF beta signaling. Phosphorylation of threonine 8 in the calmodulin-binding region of the MH1 domain by extracellular signal regulated kinase 1 (ERK1) enhances SMAD2 transcriptional activity, which is negatively regulated by calmodulin. In response to the TGF-beta signal, SMAD2 is phosphorylated by the TGF-beta receptors. The phosphorylation induces the dissociation of this protein with SARA and the association with the family member SMAD4. The association with SMAD4 is important for the translocation of this protein into the nucleus, where it binds to target promoters and forms a transcription repressor complex with other cofactors. SMAD2 can also be phosphorylated by activin type 1 receptor kinase, and mediates the signal from the activin. Alternatively spliced transcript variants encoding the SMAD2 protein have been observed.
仅用于科研。不用于诊断过程。未经明确授权不得转售。
生物信息学
蛋白别名: hMAD-2; JV18-1; MAD; MAD homolog 2; Mad protein homolog; Mad-related protein 2; MGC22139; MGC34440; mMad2; mother against DPP homolog 2; Mothers against decapentaplegic homolog 2; mothers against DPP homolog 2; pSMAD2; Sma- and Mad-related protein 2; SMAD; SMAD 2; SMAD family member 2; SMAD, mothers against DPP homolog 2; Smad2Deltaexon3; unnamed protein product
基因别名: 7120426M23Rik; CHTD8; hMAD-2; hSMAD2; JV18; JV18-1; LDS6; MADH2; MADR2; mMad2; Smad-2; SMAD2
UniProt ID: (Human) Q15796, (Mouse) Q62432, (Rat) O70436
Entrez Gene ID: (Human) 4087, (Mouse) 17126, (Rat) 29357